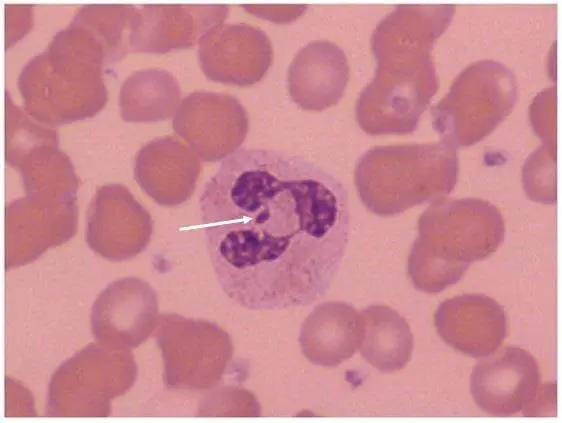
圖片描述

周邊血液抹片染色如圖,有關此白血球細胞核的不明突起物(箭頭處),下列敘述何者最適當?
詳細解析
本題觀念:
本題核心在於認識中性白血球核內可見的「鼓槌狀核突起(drumstick appendage)」,即Barr body(性染色質體)的細胞學意義與臨床判讀。
影像分析:
從血液抹片可見一顆成熟的中性白血球,其核呈分葉狀(lobulated),約有3–4個葉片,葉片之間由細絲相連。箭頭所指為其中一枚核葉上附著的小圓形致密結構,形態類似鼓槌(drumstick),大小約1µm。此結構位於核外緣,與典型的Döhle body(淡藍色偏質內包涵體)不同,因為它呈染色質濃縮塊狀,與染色質連續。周圍紅血球形態正常,無明顯巨紅芽球或巨核凋亡等改變。
選項分析
-
選項A 「與 leukemoid reaction 有關」
Leukemoid reaction 時,中性球常伴隨核左移、Döhle bodies(淡藍色或灰藍色的粗大嗜天青顆粒樣包涵體),但不出現鼓槌狀核突起。此處所見為染色質塊,不屬於Döhle bodies,故此選項不符。 -
選項B 「與 X chromosome 有關」
Barr body(sex chromatin)即因女性細胞中第二條X染色體被緊密異染色質化所形成,於中性球核外緣可見鼓槌狀附屬物。此現象僅見於具有兩條或以上X染色體的個體(正常女性、Klinefelter syndrome 等),是X染色質體的細胞學表現 (labpedia.net)。 -
選項C 「此細胞來自男性個體」
男性正常僅有一條X染色體,無Barr body,因此不會出現鼓槌狀核突起。若在男性細胞見到類似結構,須考慮異常性核型(如47,XXY),並非正常男性,故此選項錯誤。 -
選項D 「此細胞與巨紅芽球性貧血(megaloblastic anemia)有關」
Megaloblastic anemia 中性球核常會過度分葉(hypersegmentation,葉片≥6),但不形成鼓槌狀性染色質體。此處核突起為性染色體異染色質,不是核分葉異常,故與megaloblastic anemia 無關。
答案解析
箭頭所指的鼓槌狀附屬物為Barr body(性染色質體),代表第二條X染色體被異染色質化後的濃縮區,在約2–3%的女性中性球可見此核突起,用於細胞學性別鑑定。本題最適當的敘述為「與 X chromosome 有關」(選項B)。
核心知識點
- Barr body(性染色質體):女性細胞中第二條X染色體異染色質化後所形成,形態於核外緣呈鼓槌狀;僅見於具有兩條或以上X染色體的個體。
- Drumstick appendage:中性白血球核上的性染色質體呈現形式,約2–3%的女性中性球可見。
- Döhle bodies vs Barr body:Döhle bodies 為細胞質嗜天青包涵,與病毒感染、炎症反應相關;Barr body 為核染色質附屬,不同組織來源及意義。
- Megaloblastic hypersegmentation:核多分葉(≥6 lobes),與維生素B12或葉酸缺乏相關,非Barr body。
臨床重要性
辨識Barr body 有助於細胞學性別鑑定,也可於遺傳性疾病(Turner syndrome、Klinefelter syndrome)輔助診斷,並避免將正常性染色質體誤判為病理性包涵體。